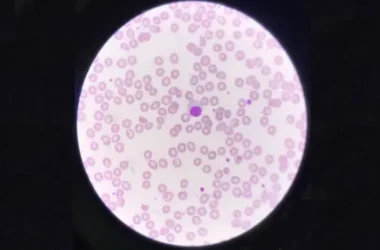

هل شعرت يومًا بألم في ركبتك يزداد سوءًا مع الحركة، أو تيبّس يجعل النهوض صباحًا مهمة صعبة؟ قد تكون هذه علامات على التهاب غضروف الركبة، وهي حالة شائعة تؤثر على ملايين الأشخاص حول العالم.
يحدث هذا التآكل التدريجي للغضروف الواقي في المفصل، مما يؤدي إلى الألم، التورم، وصعوبة الحركة. في هذا المقال، نأخذك في رحلة متكاملة لتفهم ماهية التهاب غضروف الركبة، أسبابه، أعراضه، وكيف يمكن إدارته بفعالية لاستعادة نشاطك وحيويتك.
- ما هو التهاب غضروف الركبة؟
- أسباب التهاب غضروف الركبة وعوامل الخطر
- أعراض التهاب غضروف الركبة
- تشخيص التهاب غضروف الركبة
- خيارات علاج التهاب غضروف الركبة
ما هو التهاب غضروف الركبة؟
يُعدّ التهاب غضروف الركبة، المعروف أيضًا بالفصال العظمي في الركبة (Osteoarthritis of the Knee)، حالة شائعة تؤثر على ملايين الأفراد عالميًا. يحدث هذا المرض عندما يتآكل الغضروف الواقي، وهو نسيج مرن يغطي نهايات العظام في المفاصل، مما يسمح لها بالانزلاق بسلاسة فوق بعضها البعض. الركبة من المفاصل الأكثر عرضة لهذا الالتهاب والتآكل.
يؤدي هذا التآكل التدريجي للغضروف إلى احتكاك العظام ببعضها مباشرة، مسببًا الألم والتيبس الذي يتفاقم مع مرور الوقت. تصبح الأنشطة اليومية البسيطة أكثر صعوبة وألمًا. يتطور التهاب غضروف الركبة ببطء شديد، ويصيب غالبًا كبار السن، لكنه قد يظهر في فئات عمرية أخرى لأسباب مختلفة.
أسباب التهاب غضروف الركبة وعوامل الخطر
لا يوجد سبب واحد ومحدد للإصابة بالتهاب غضروف الركبة، بل هو نتيجة لتفاعل عدة عوامل تزيد من خطر تطوره. فهم هذه العوامل يساعد في الوقاية وإدارة الحالة بفعالية:
- التقدم في العمر: مع التقدم في السن، يزداد احتمال تآكل الغضروف، مما يجعله العامل الأكثر شيوعًا.
- الجنس: النساء أكثر عرضة للإصابة بالتهاب غضروف الركبة مقارنة بالرجال، خاصة بعد سن الخمسين.
- زيادة الوزن أو السمنة: يضع الوزن الزائد حملاً إضافيًا وضغطًا كبيرًا على مفاصل الركبة، مما يسرع من تآكل الغضاريف.
- الإجهاد البدني المتكرر: المهن التي تتطلب حركات متكررة أو حمل أثقال، مثل الزراعة أو بعض أنواع العمل اليدوي، تزيد من إجهاد الركبة.
- الإصابات السابقة في الركبة: كسور العظام التي تمتد إلى المفصل، إصابات الأربطة، أو الغضاريف الهلالية يمكن أن تزيد من خطر التهاب الغضروف لاحقًا.
- الوراثة: إذا كان هناك تاريخ عائلي للإصابة بالتهاب المفاصل العظمي، فقد تكون أكثر عرضة لتطوره.
- بعض الأمراض المزمنة: حالات مثل النقرس أو التهاب المفاصل الروماتويدي قد تزيد من خطر تآكل الغضاريف.
- تشوهات العظام: العيوب الخلقية في شكل الركبة أو محاذاة العظام يمكن أن تؤدي إلى توزيع غير متساوٍ للوزن وتآكل مبكر.
أعراض التهاب غضروف الركبة
تتطور أعراض التهاب غضروف الركبة تدريجيًا على مدار أشهر أو حتى سنوات. انتبه لهذه العلامات الشائعة التي قد تشير إلى هذه الحالة:
- الألم: غالبًا ما يكون الألم هو العرض الأول والأكثر إزعاجًا. يزداد سوءًا مع الحركة أو بعد النشاط، ويتحسن بالراحة. قد تشعر به عند الضغط على المفصل.
- التيبس: تلاحظ تيبسًا في الركبة، خاصة في الصباح أو بعد فترات طويلة من الجلوس أو عدم النشاط. عادة ما يتحسن التيبس بعد بضع دقائق من بدء الحركة.
- فقدان المرونة ونطاق الحركة: قد تجد صعوبة في ثني ركبتك أو فردها بالكامل. هذا يؤثر على قدرتك على المشي، صعود الدرج، أو الجلوس بشكل مريح.
- أصوات الطقطقة أو الاحتكاك: قد تسمع أو تشعر بأصوات طقطقة، فرقعة، أو احتكاك داخل المفصل عند تحريكه. هذه الأصوات تشير إلى خشونة السطح الغضروفي.
- التورم: يمكن أن تتجمع السوائل حول المفصل المصاب، مما يؤدي إلى تورم مرئي وشعور بالامتلاء أو الضغط.
- الحساسية عند اللمس: قد يكون المفصل مؤلمًا عند لمسه أو الضغط عليه.
- تشكل النتوءات العظمية (نتوءات العظم): مع تقدم المرض، قد تتشكل نتوءات عظمية صغيرة حول المفصل، والتي قد تشعر بها أحيانًا تحت الجلد.
تشخيص التهاب غضروف الركبة
يبدأ تشخيص التهاب غضروف الركبة دائمًا بأخذ تاريخك الطبي المفصل وإجراء فحص سريري دقيق. سيستفسر طبيبك عن أعراضك، متى بدأت، وما الذي يزيدها سوءًا أو يحسنها. بعد ذلك، قد يطلب طبيبك فحوصات إضافية لتأكيد التشخيص وتقييم مدى تلف الغضروف:
- الأشعة السينية (X-rays): تعد الأشعة السينية ضرورية لتقييم حالة المفصل. يمكنها إظهار ضيق المسافة بين العظام (مؤشر على تآكل الغضروف)، وتغيرات في العظام، ووجود نتوءات عظمية.
- التصوير بالرنين المغناطيسي (MRI): يوفر الرنين المغناطيسي صورًا أكثر تفصيلاً للأنسجة الرخوة، بما في ذلك الغضروف، الأربطة، والأوتار. يساعد هذا الفحص في الكشف عن التلف المبكر للغضروف ويقيم الأضرار التي قد لا تظهر في الأشعة السينية.
- اختبارات الدم: لا يوجد فحص دم محدد لتشخيص التهاب غضروف الركبة، لكنها تستخدم لاستبعاد حالات أخرى تسبب آلام المفاصل، مثل النقرس أو التهاب المفاصل الروماتويدي.
- تحليل سائل المفصل (Joint Fluid Analysis): في بعض الحالات، قد يسحب طبيبك عينة من السائل داخل المفصل (البزل المفصلي) لفحصها تحت المجهر. يساعد هذا الفحص في تحديد سبب الالتهاب واستبعاد حالات مثل العدوى أو النقرس.
خيارات علاج التهاب غضروف الركبة
مع الأسف، لا يوجد علاج شافٍ تمامًا لالتهاب غضروف الركبة، ولا يمكن استعادة الغضروف التالف إلى حالته الأصلية. ومع ذلك، تهدف خطط العلاج إلى تخفيف الألم، تحسين وظيفة الركبة، وإبطاء تطور المرض. تتنوع هذه الخيارات لتناسب احتياجات كل فرد، وتشمل ما يلي:
العلاج غير الدوائي
تُعدّ التغييرات في نمط الحياة والعلاجات الطبيعية حجر الزاوية في إدارة التهاب غضروف الركبة، وهي غالبًا ما تكون الخطوة الأولى في العلاج:
- تخفيف الوزن: فقدان الوزن الزائد يقلل بشكل كبير من الضغط الواقع على مفاصل الركبة، مما يساهم في تخفيف الألم وتحسين الحركة.
- النشاط البدني المنتظم: ممارسة التمارين منخفضة التأثير مثل المشي، السباحة، أو ركوب الدراجات الثابتة تقوي العضلات المحيطة بالركبة وتحافظ على مرونة المفصل.
- العلاج الطبيعي: يساعد أخصائي العلاج الطبيعي على تصميم برنامج تمارين مخصص لتقوية عضلات الفخذ والساق، وزيادة نطاق حركة الركبة، وتحسين التوازن.
- العلاج بالحرارة والبرودة: استخدام الكمادات الدافئة يقلل من تيبس المفصل، بينما يساعد الثلج في تخفيف الألم والتورم بعد النشاط.
- الكمادات الموضعية: يمكن أن توفر الكريمات والمراهم التي تحتوي على مكونات مثل الكابسيسين أو المنثول راحة مؤقتة من الألم عند تطبيقها مباشرة على الركبة.
- استخدام أجهزة المساعدة: قد يوصي طبيبك باستخدام عصا أو مشاية للمساعدة في تقليل الضغط على الركبة المصابة أثناء المشي.
العلاج الدوائي
يمكن أن تساعد الأدوية في تخفيف الألم والالتهاب المرتبط بالتهاب غضروف الركبة، وتشمل:
- مسكنات الألم المتاحة دون وصفة طبية: مثل الباراسيتامول، يمكن أن توفر راحة من الألم الخفيف إلى المتوسط.
- الأدوية المضادة للالتهاب غير الستيرويدية (NSAIDs): مثل الإيبوبروفين أو النابروكسين، تقلل الألم والالتهاب. تتوفر هذه الأدوية أيضًا بوصفة طبية بجرعات أعلى.
- حقن الكورتيزون: يحقن الكورتيزون مباشرة في المفصل لتخفيف الألم والالتهاب بشكل سريع ومؤقت.
- حقن حمض الهيالورونيك: تُحقن هذه المادة الشبيهة بالهلام في الركبة لتليين المفصل وتوفير وسادة، مما قد يقلل الألم ويحسن الحركة لبعض المرضى.
العلاج الجراحي
عندما لا تنجح العلاجات غير الجراحية في تخفيف الألم وتحسين نوعية الحياة، قد يصبح التدخل الجراحي ضروريًا. تتضمن الخيارات الجراحية ما يلي:
- تنظير المفصل: على الرغم من أنه لا يُوصى به عادة كعلاج طويل الأمد لالتهاب المفاصل العظمي، إلا أنه يمكن استخدامه لإزالة الأنسجة التالفة أو النتوءات العظمية التي تسبب الألم والمحدودية في الحركة.
- رأب العظم (Osteotomy): إذا كان التلف يقتصر على جانب واحد من الركبة، قد يقوم الجراح بقطع جزء من عظم الساق أو الفخذ وإعادة تشكيله لتغيير توزيع الوزن على المفصل الصحي، مما يخفف الضغط عن الجزء التالف.
- ترقيع الغضروف (Cartilage Grafting): يُعد هذا الخيار مناسبًا للمرضى الأصغر سنًا الذين يعانون من عيوب غضروفية محدودة. يتضمن نقل غضروف سليم من منطقة أخرى من المفصل أو من متبرع لملء الفجوة في الغضروف التالف.
- استبدال مفصل الركبة (Total or Partial Knee Replacement): يُعتبر هذا الإجراء هو الحل النهائي للحالات الشديدة من التهاب غضروف الركبة. يقوم الجراح بإزالة الغضروف والعظم التالف واستبدالهما بمكونات معدنية وبلاستيكية لاستعادة وظيفة الركبة وتخفيف الألم بشكل كبير.
يُعد التهاب غضروف الركبة حالة مزمنة تتطلب إدارة مستمرة، لكن فهمك لها ولالتزامك بالخطة العلاجية يمنحانك القدرة على التحكم في الأعراض وتحسين نوعية حياتك. تذكر أن التشخيص المبكر والتعاون الوثيق مع طبيبك هما مفتاح الحفاظ على حركة ركبتك وتقليل الألم. لا تتردد في طلب المشورة الطبية إذا كنت تعاني من أي من الأعراض المذكورة.